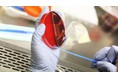

カイ・ベックマンがメルクグループ経営執行委員会 会長 兼CEOに就任2026年5月1日付 メルク新経…
 メルクグループジャパン
メルクグループジャパン メルクグループジャパン
メルクグループジャパン 第77回日本生物工学会大会実行委員会
第77回日本生物工学会大会実行委員会 メルクエレクトロニクス株式会社
メルクエレクトロニクス株式会社 株式会社ハンズ
株式会社ハンズ アサヒビール株式会社
アサヒビール株式会社 株式会社コネクト・インターナショナル
株式会社コネクト・インターナショナル ハイケム株式会社
ハイケム株式会社 メルクエレクトロニクス株式会社
メルクエレクトロニクス株式会社 株式会社ハンズ
株式会社ハンズ 第76回日本生物工学会大会
第76回日本生物工学会大会 メルクエレクトロニクス株式会社
メルクエレクトロニクス株式会社 株式会社バンダイ ベンダー事業部
株式会社バンダイ ベンダー事業部 株式会社ユー・メディコ
株式会社ユー・メディコ 株式会社MIOJIO
株式会社MIOJIO E.OCT株式会社
E.OCT株式会社 メルクエレクトロニクス株式会社
メルクエレクトロニクス株式会社 株式会社スマイルズ
株式会社スマイルズ 株式会社ロフト
株式会社ロフト メルクエレクトロニクス株式会社
メルクエレクトロニクス株式会社 STRADVISION,INC
STRADVISION,INC メルクエレクトロニクス株式会社
メルクエレクトロニクス株式会社 メルクエレクトロニクス株式会社
メルクエレクトロニクス株式会社 メルクエレクトロニクス株式会社
メルクエレクトロニクス株式会社 メルクエレクトロニクス株式会社
メルクエレクトロニクス株式会社 Report Ocean
Report Ocean メルクエレクトロニクス株式会社
メルクエレクトロニクス株式会社 Report Ocean
Report Ocean Report Ocean
Report Ocean GII
GII Report Ocean
Report Ocean メルクパフォーマンスマテリアルズ合同会社
メルクパフォーマンスマテリアルズ合同会社 Report Ocean
Report Ocean Report Ocean
Report Ocean メルクパフォーマンスマテリアルズ合同会社
メルクパフォーマンスマテリアルズ合同会社 株式会社エイ出版社
株式会社エイ出版社 公益財団法人日本対がん協会
公益財団法人日本対がん協会 腸内フローラ移植臨床研究株式会社
腸内フローラ移植臨床研究株式会社 腸内フローラ移植臨床研究株式会社
腸内フローラ移植臨床研究株式会社 腸内フローラ移植臨床研究株式会社
腸内フローラ移植臨床研究株式会社 メルクパフォーマンスマテリアルズ合同会社
メルクパフォーマンスマテリアルズ合同会社